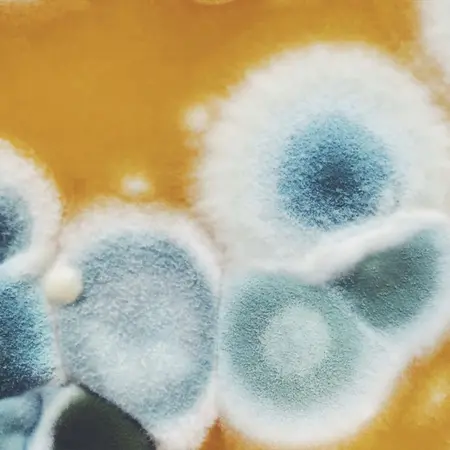

Alergia
Las alergias son una respuesta exagerada del sistema inmune frente un agente externo, denominado en términos clínicos como antígeno, aunque para la población general este elemento externo se conoce como alérgeno.
Si bien la primavera es una estación famosa por la presencia de síntomas alérgicos en gran parte de la población tanto infantil como adulta, la alergia no sólo está presente en esta estación, sino que puede manifestarse durante todo el año, dependiendo del tipo de alergeno y de la sensibilidad de cada persona
La alergia es básicamente una reacción exagerada del cuerpo ante algo que, en teoría, no debería molestarnos: el polvo, el polen, ciertos alimentos, animales, medicamentos, etc... la lista puede ser larga. Es el sistema inmunológico que, por causas genéticas gatilladas por factores ambientales, comienza a defenderse de algo que no es realmente peligroso. El cuerpo lo identifica como una amenaza y reacciona liberando histamina y otros mediadores inflamatorios, lo que genera síntomas variados tanto en su presentación como en su intensidad.
Desde la perspectiva médica, las alergias se dividen en dos grandes grupos:
1. Alergias estacionales:
Estas se presentan en momentos específicos del año, cuando ciertos alérgenos están más presentes en el ambiente. Por ejemplo:
- Primavera: polen de árboles como el olivo, el abedul o el roble.
- Verano: polen de gramíneas y césped.
- Otoño: polen de malezas como la ambrosía y esporas de moho.
- Invierno: aunque menos común, algunas plantas como el ciprés pueden liberar polen, y los ambientes interiores favorecen la exposición a otros alérgenos.
2. Alergias perennes (todo el año):
Estas son causadas por alérgenos que están presentes de forma constante, como:
Estas alergias no dependen de la estación y pueden generar síntomas persistentes o intermitentes durante todo el año.
Los síntomas alérgicos pueden presentarse en distintos niveles:
Estos síntomas no sólo son molestos, sino que pueden interferir con actividades cotidianas como dormir, trabajar, estudiar o disfrutar del tiempo libre. Por ejemplo, las personas con alergias perennes pueden experimentar síntomas crónicos como congestión nasal, estornudos, picazón ocular o tos, lo que impacta el sueño, el rendimiento laboral y el bienestar emocional. En cambio, quienes tienen alergias estacionales suelen sufrir peaks intensos de síntomas durante ciertas épocas, lo que también puede ser muy limitante. Quien sufre alergia alimentaria vive con la constante preocupación de evitar ciertos ingredientes, lo que limita su vida social y emocional.